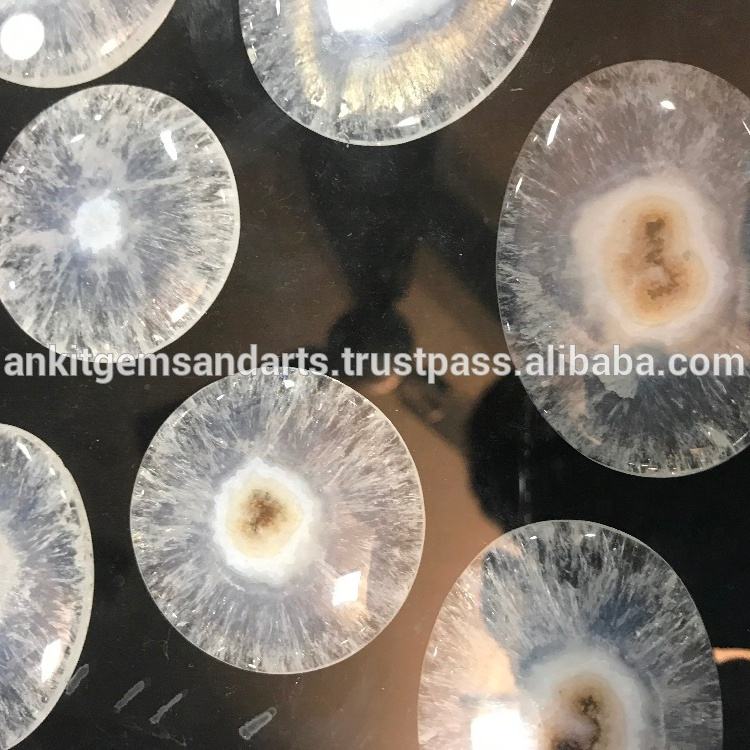

Attributs
CabochonsForme de pierre gemme
QuartzMatériel de pierre gemme
NaturelType de pierre gemme
AucunType de certificat
AucunTraitements appliqués
N/AEffets spéciaux optiques
Point d'origine:Various
Marque nom:Ankit Gems & Arts
Numéro de Type:N/a
Couleur de Pierre Gemme:Blanc
Dimension de Pierre Gemme:Toutes les tailles
Poids de Pierre Gemme:Taille libre
Hauteur de l'article:N/A
Trou Diamètre:N/A
Utilisation:Colliers, boucles d'oreilles, bracelets, etc
Qualité:AAAAA
Application:Guérison, anneaux, pendentifs
Nom du produit:Quartz solaire











